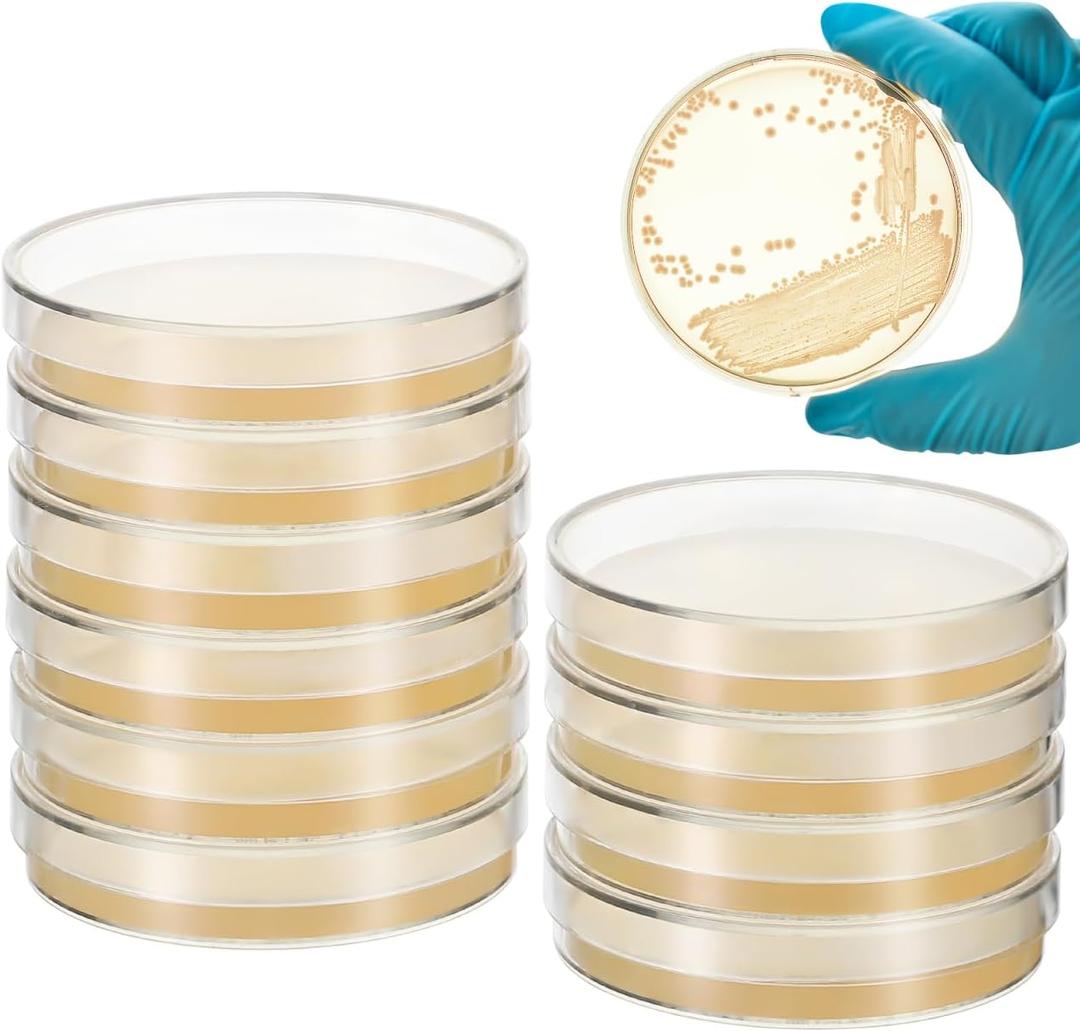
Baluue 10Pcs Nutrient Agar Petri Dishes Science Project Kit, 70mm Pre-Poured Agar Plates, Laboratory Experiment Prepoured Supplies for Students (7CX7cm)

Baluue 10Pcs Nutrient Agar Petri Dishes Science Project Kit, 70mm Pre-Poured Agar Plates, Laboratory Experiment Prepoured Supplies for Students (7CX7cm)
Condition: New
Pickup Details
| Saturday, Nov 15 | 08:30AM - 02:00PM |
| Monday, Nov 17 | 11:00AM - 06:30PM (Appointment only) |
| Tuesday, Nov 18 | 12:00PM - 06:30PM |
| Wednesday, Nov 19 | 11:00AM - 06:30PM (Appointment only) |
Product Details
| SKU | OLARR5457889 |
| ASIN | B0CPQ8V1GJ |